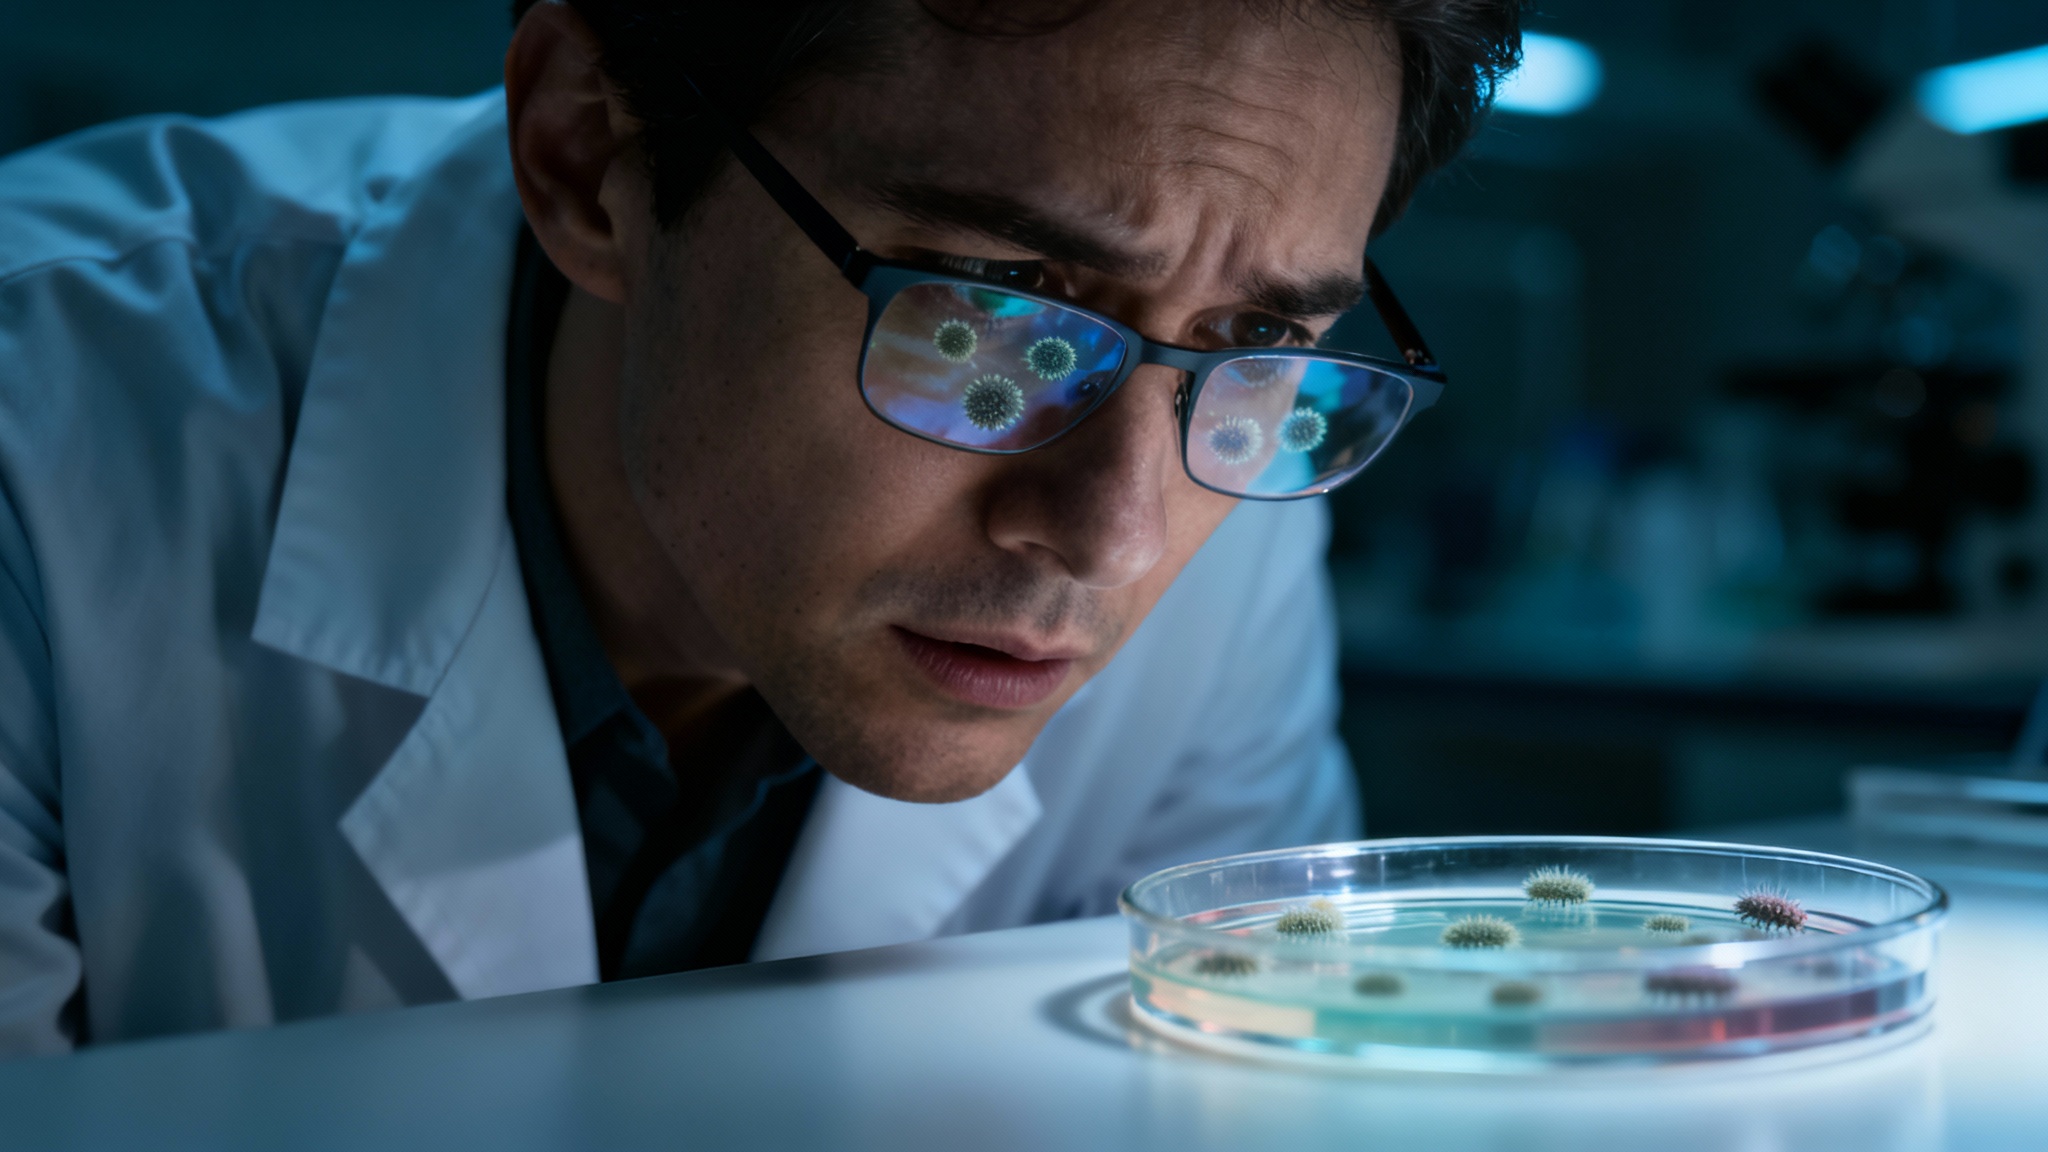

Superbactéries : la menace silencieuse qui pourrait faire 40 millions de morts par an d’ici 2050
Auteur: Adam David
La bombe à retardement est déjà amorcée
Un bilan humain plus lourd que le cancer

L’autre crise : un séisme économique mondial

Mais l’impact ne sera pas que sanitaire. La facture économique s’annonce, elle aussi, colossale. Le Center for Global Development (CGD) estime les pertes pour le PIB mondial à 1 700 milliards de dollars chaque année. Personne ne sera épargné. La Chine pourrait perdre 722 milliards par an, les États-Unis 296 milliards, et l’Union européenne 187 milliards. Il faut imaginer des systèmes de santé saturés, une productivité en chute libre et des coûts qui explosent. Un scénario noir qui transformerait cette crise de santé publique en un véritable marasme économique global.
Des hôpitaux déjà sous tension

Le Dr Mohsen Naghavi, de l’Institute for Health Metrics and Evaluation, le résume sans détour dans les colonnes du Guardian : « Sans action immédiate, les médicaments actuels pourraient devenir inefficaces, transformant une simple infection en condamnation à mort ». Une médecine à deux vitesses pourrait alors s’installer, où seuls les plus riches auraient accès aux traitements capables de les sauver.
Le paradoxe des coupes budgétaires

La logique est pourtant simple, presque cruelle : un foyer de résistance qui se développe en Asie ou en Afrique ne restera pas confiné. Tôt ou tard, il atteindra l’Europe ou l’Amérique du Nord. En affaiblissant les systèmes de santé des pays du Sud, on se tire une balle dans le pied, préparant le terrain à une pandémie incontrôlable.
agir maintenant, le seul pari rationnel

Agir ne relève donc pas de la générosité, mais du pragmatisme. La fenêtre d’opportunité pour éviter que des décennies de progrès médical ne soient anéanties se referme peu à peu. La question n’est plus de savoir si nous devons agir, mais si nous aurons le courage de le faire avant qu’il ne soit trop tard.